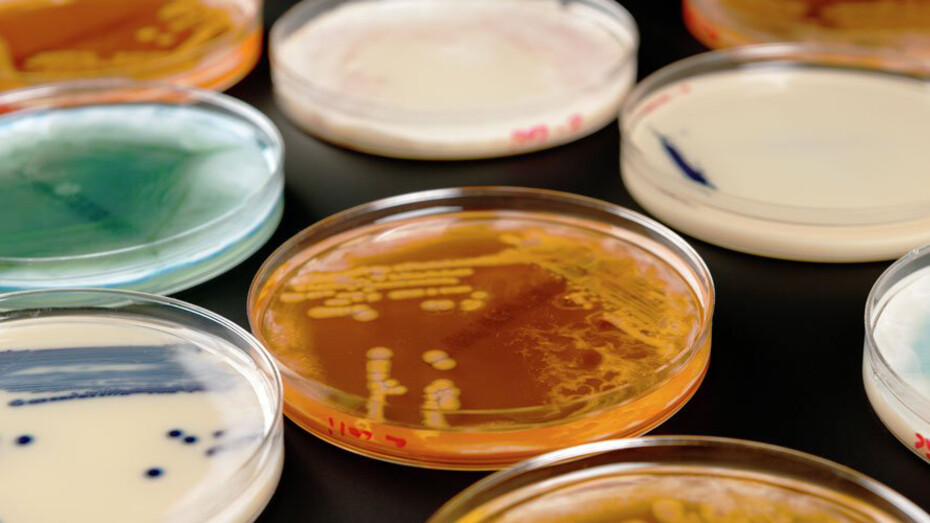
Superbugs. Courtesy of Science Museum

Antibiotics have enabled us to combat diseases that were once untreatable. But bacteria have fought back, evolving into superbugs resistant to even the most powerful antibiotics.
Our new exhibition explores how society is responding to the enormous challenge of antibiotic resistance, featuring scientific research from across the globe and the personal stories of those waging war on the superbugs.